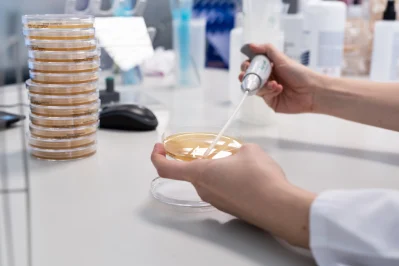

Análisis
Biología Molecular
En nuestra área de Biología Molecular empleamos la última tecnología, desarrollada por Kary Mullín (premio Nobel en 1993), PCR Real Time.
Esta novedosa técnica ha sido reconocida como una de las más potentes y rápidas en el campo de la biología molecular, incluyendo todas las fases del análisis (concentración de la muestra, extracción del DNA y “PCR en tiempo real”).
Contamos con equipos de alta precisión de trabajo, que incluye un termociclador con sistema de detección de secuencias en tiempo real, que nos permite garantizar la obtención de resultados en un plazo máximo de 24- 48 horas desde la recepción de la muestra para el análisis cualitativo y cuantitativo de Legionella Pneumophila y la detección especifica de Salmonella entérica.
Nuestra área de Biología Molecular está situada en una zona del laboratorio específicamente diseñada para ello y que reúne todas las condiciones de seguridad que precisa la aplicación de la técnica PCR Real Time.